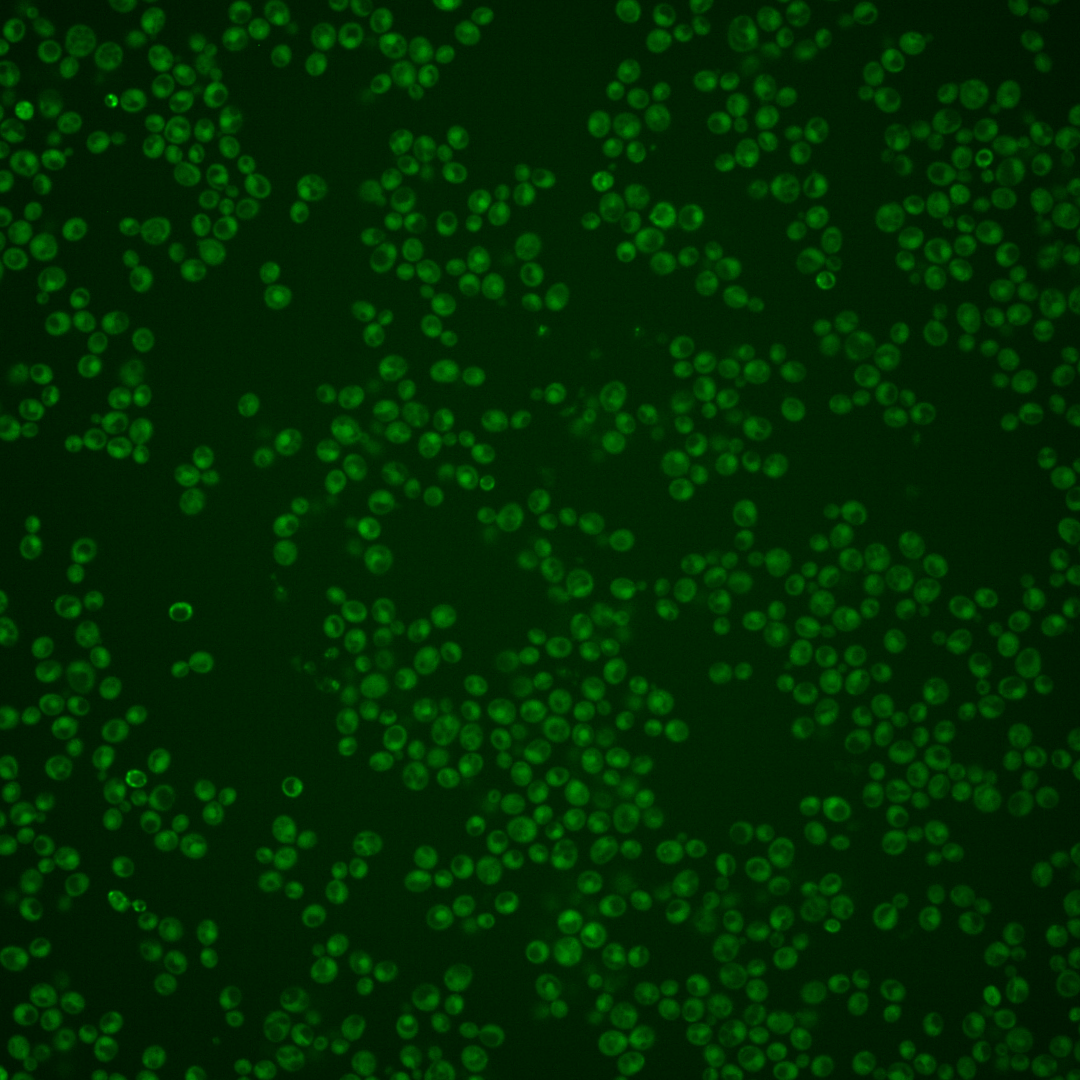
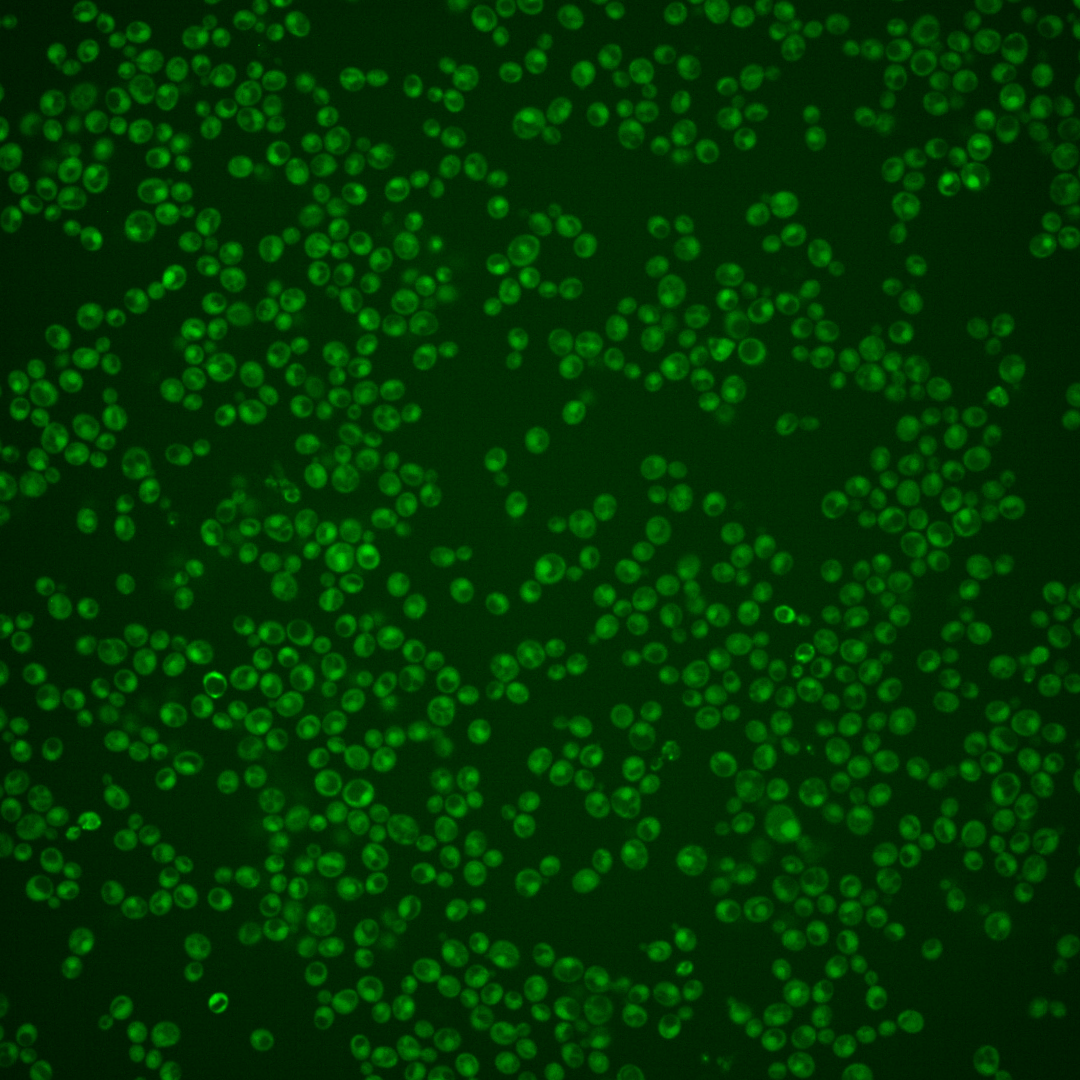
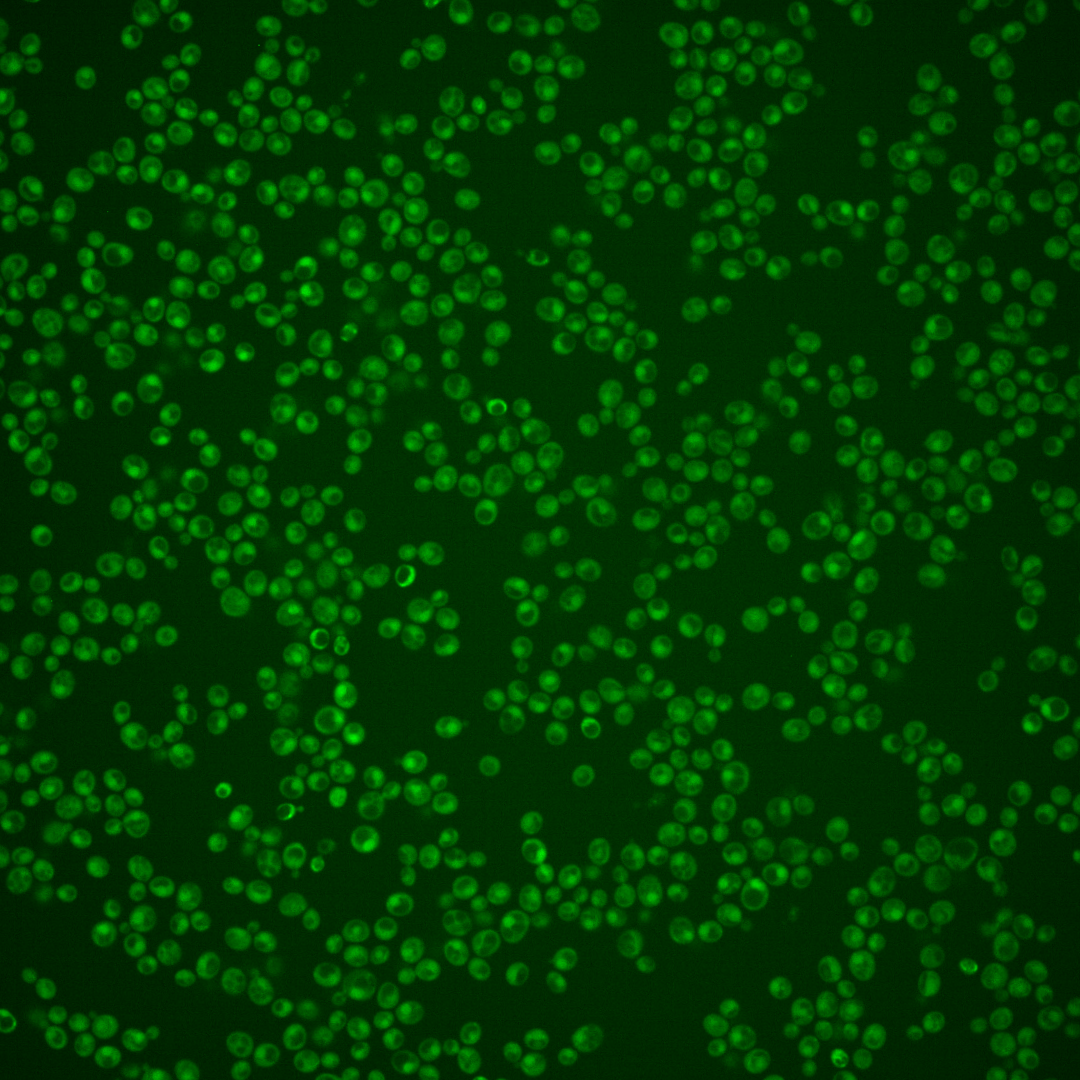
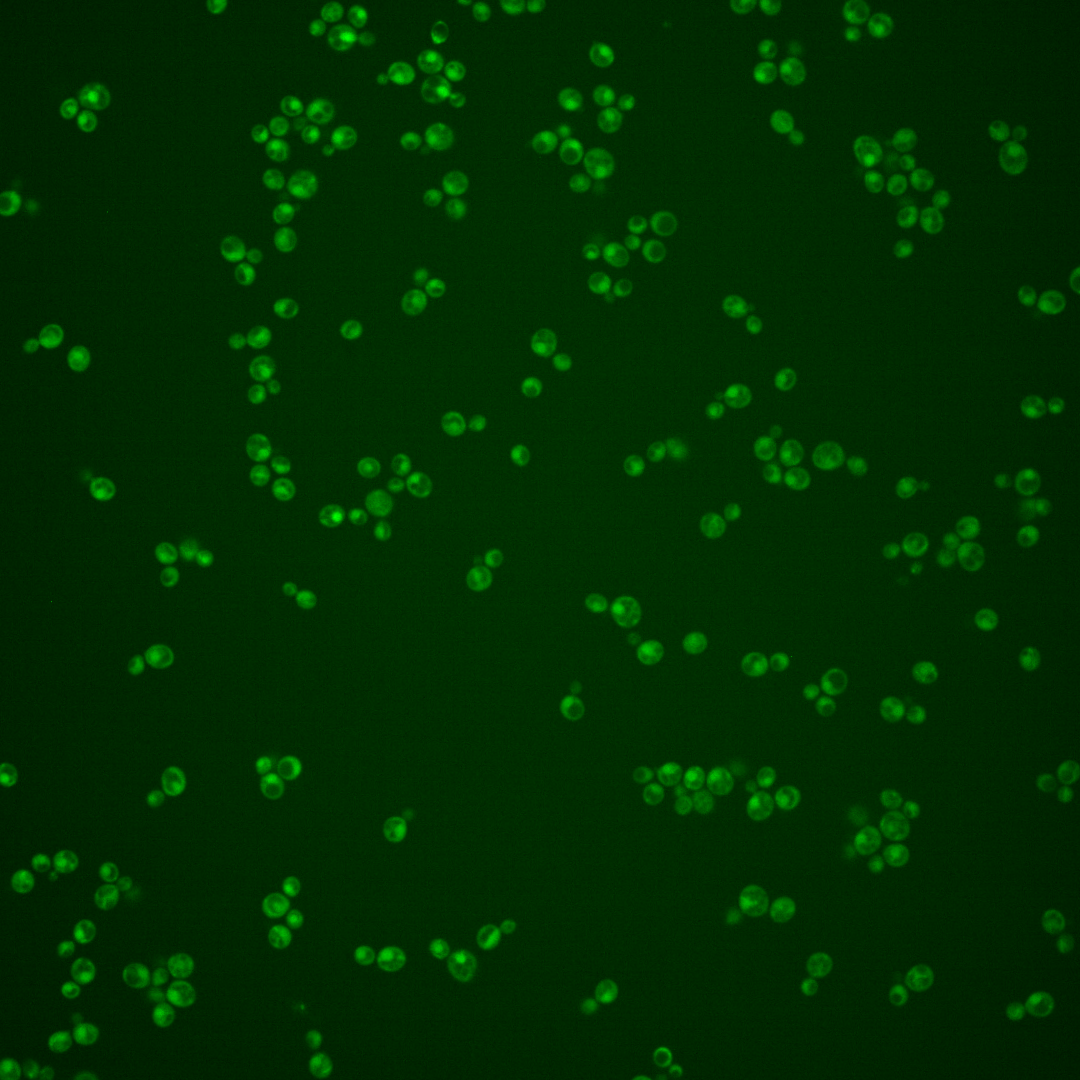
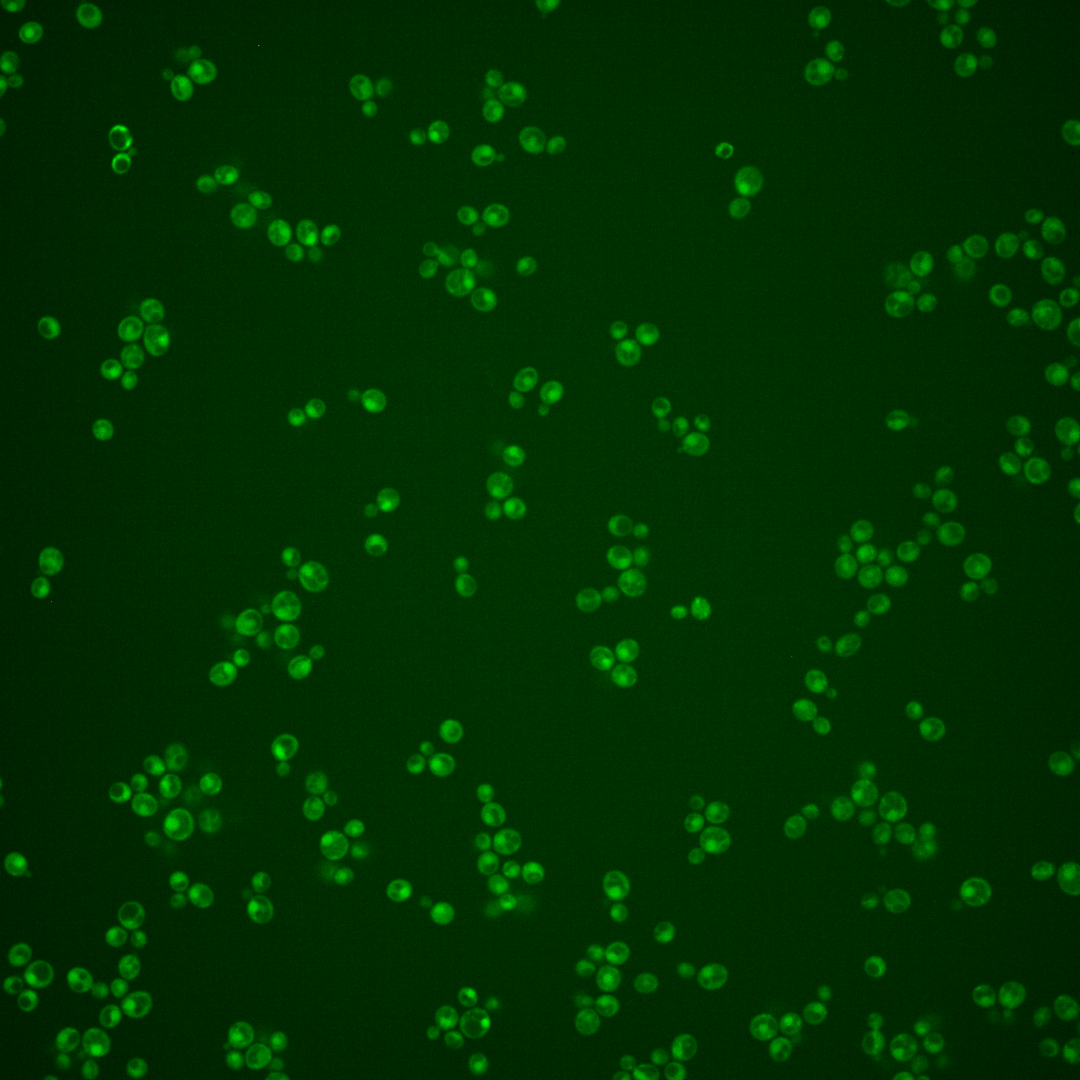

| Standard name | |
|---|---|
| Human Ortholog | |
| Description | Phosphotyrosine-specific phosphatase; major role in osmolarity sensing through dephosphorylation of the Hog1p MAPK with a minor role by Ptp3p; inactivates and regulates Hog1p localization; major role in the cell wall integrity pathway through dephosphorylation of MAPK Slt2p with a minor role by Ptp3p; minor role with Msg5p in the pheromone adaptive response through dephosphorylation of MAPK Fus3p with major role by Ptp3p; co-regulates the calcium signaling pathway with Msg5p; nuclear localized |
Micrographs




















































































Sub-cellular Localization
Yeast GFP Assignment
Protein Abundance
Localization Change
External localization resources
| ensLOC | DeepLoc | |||||||||||||||||||||||
|---|---|---|---|---|---|---|---|---|---|---|---|---|---|---|---|---|---|---|---|---|---|---|---|---|
| Localization | WT1 | WT2 | WT3 | RAP60 | RAP140 | RAP220 | RAP300 | RAP380 | RAP460 | RAP540 | RAP620 | RAP700 | HU80 | HU120 | HU160 | rpd3Δ_1 | rpd3Δ_2 | rpd3Δ_3 | WT1 | WT2 | WT3 | AF100 | AF140 | AF180 |
| Cortical Patches | 0 | 0 | 0 | 0 | 0 | 0 | 0 | 0 | 0 | 0 | 0 | 0 | 0 | 0 | 0 | 0 | 0 | 0 | 0 | 1 | 1 | 1 | 6 | 3 |
| Bud | 1 | 0 | 0 | 0 | 0 | 1 | 3 | 5 | 6 | 11 | 8 | 7 | 0 | 0 | 0 | 0 | 0 | 1 | 0 | 0 | 1 | 0 | 10 | 12 |
| Bud Neck | 0 | 0 | 6 | 3 | 3 | 3 | 8 | 11 | 0 | 2 | 5 | 10 | 0 | 0 | 0 | 0 | 0 | 0 | 0 | 1 | 1 | 0 | 6 | 12 |
| Bud Site | 0 | 0 | 1 | 0 | 0 | 0 | 1 | 5 | 4 | 7 | 5 | 5 | 0 | 0 | 0 | 0 | 0 | 0 | – | – | – | – | – | – |
| Cell Periphery | 0 | 0 | 0 | 0 | 1 | 0 | 1 | 0 | 1 | 1 | 0 | 1 | 0 | 1 | 1 | 0 | 0 | 0 | 0 | 0 | 0 | 0 | 1 | 0 |
| Cytoplasm | 62 | 96 | 156 | 117 | 97 | 119 | 132 | 136 | 62 | 76 | 92 | 124 | 195 | 302 | 289 | 51 | 49 | 13 | 48 | 94 | 127 | 70 | 181 | 181 |
| Endoplasmic Reticulum | 1 | 1 | 0 | 0 | 0 | 0 | 2 | 0 | 0 | 2 | 2 | 1 | 0 | 3 | 1 | 4 | 2 | 2 | 0 | 0 | 2 | 2 | 6 | 2 |
| Endosome | 0 | 0 | 1 | 0 | 1 | 3 | 0 | 2 | 0 | 0 | 0 | 0 | 3 | 3 | 0 | 3 | 6 | 1 | 2 | 0 | 2 | 1 | 2 | 2 |
| Golgi | 0 | 0 | 0 | 0 | 0 | 0 | 0 | 0 | 0 | 0 | 0 | 0 | 0 | 0 | 0 | 1 | 1 | 0 | 0 | 0 | 0 | 0 | 1 | 2 |
| Mitochondria | 25 | 43 | 2 | 21 | 14 | 82 | 140 | 84 | 172 | 179 | 215 | 143 | 20 | 14 | 25 | 4 | 3 | 1 | 7 | 6 | 19 | 11 | 21 | 13 |
| Nucleus | 8 | 9 | 7 | 11 | 48 | 101 | 140 | 97 | 67 | 53 | 73 | 54 | 5 | 4 | 10 | 21 | 22 | 6 | 31 | 28 | 30 | 10 | 13 | 18 |
| Nuclear Periphery | 2 | 0 | 0 | 0 | 0 | 0 | 1 | 0 | 0 | 1 | 1 | 0 | 0 | 0 | 0 | 0 | 0 | 0 | 0 | 0 | 0 | 0 | 0 | 1 |
| Nucleolus | 0 | 0 | 0 | 1 | 0 | 0 | 1 | 0 | 0 | 0 | 1 | 0 | 0 | 0 | 0 | 2 | 2 | 0 | 0 | 0 | 0 | 0 | 1 | 0 |
| Peroxisomes | 0 | 0 | 0 | 0 | 0 | 0 | 0 | 0 | 0 | 0 | 0 | 0 | 0 | 0 | 0 | 0 | 0 | 0 | 0 | 0 | 0 | 0 | 1 | 1 |
| SpindlePole | 0 | 0 | 1 | 1 | 1 | 3 | 2 | 8 | 1 | 2 | 0 | 3 | 0 | 0 | 0 | 0 | 0 | 0 | 1 | 3 | 4 | 1 | 9 | 12 |
| Vac/Vac Membrane | 28 | 11 | 13 | 3 | 30 | 36 | 27 | 19 | 8 | 17 | 15 | 14 | 77 | 115 | 91 | 47 | 55 | 24 | 33 | 38 | 62 | 42 | 102 | 74 |
| Unique Cell Count | 101 | 142 | 179 | 147 | 185 | 282 | 375 | 307 | 235 | 270 | 322 | 291 | 272 | 393 | 379 | 119 | 120 | 40 | 129 | 184 | 262 | 150 | 377 | 345 |
| Labelled Cell Count | 127 | 160 | 187 | 157 | 195 | 348 | 458 | 367 | 321 | 351 | 417 | 362 | 300 | 442 | 417 | 133 | 140 | 48 | 129 | 184 | 262 | 150 | 377 | 345 |
Yeast GFP Assignment
Protein Abundance
| Screen | WT1 | WT2 | WT3 | RAP60 | RAP140 | RAP220 | RAP300 | RAP380 | RAP460 | RAP540 | RAP620 | RAP700 | HU80 | HU120 | HU160 | rpd3Δ_1 | rpd3Δ_2 | rpd3Δ_3 | AF100 | AF140 | AF180 |
|---|---|---|---|---|---|---|---|---|---|---|---|---|---|---|---|---|---|---|---|---|---|
| Mean Cell GFP Intensity (1e-4) | 3.9 | 3.3 | 4.6 | 4.2 | 4.9 | 3.9 | 4.0 | 4.2 | 3.3 | 3.4 | 3.2 | 3.7 | 4.1 | 4.3 | 4.5 | 6.4 | 6.6 | 6.4 | 4.3 | 4.4 | 4.8 |
| Std Deviation (1e-4) | 0.6 | 0.4 | 0.9 | 1.1 | 1.2 | 0.9 | 0.9 | 1.1 | 0.7 | 1.2 | 0.8 | 1.0 | 0.7 | 0.9 | 1.3 | 1.2 | 1.4 | 1.5 | 1.7 | 1.6 | 1.5 |
| Intensity Change (Log2) | – | – | – | -0.13 | 0.11 | -0.22 | -0.2 | -0.13 | -0.48 | -0.44 | -0.49 | -0.31 | -0.15 | -0.1 | -0.03 | 0.48 | 0.52 | 0.49 | -0.1 | -0.07 | 0.06 |
Localization Change
| Localization | RAP60 | RAP140 | RAP220 | RAP300 | RAP380 | RAP460 | RAP540 | RAP620 | RAP700 | HU80 | HU120 | HU160 | rpd3Δ_1 | rpd3Δ_2 | rpd3Δ_3 |
|---|---|---|---|---|---|---|---|---|---|---|---|---|---|---|---|
| Actin | – | – | – | – | – | – | – | – | – | – | – | – | – | – | – |
| Bud | – | – | – | – | – | – | – | – | – | – | – | – | 0 | 0 | 0 |
| Bud Neck | – | – | – | – | – | – | – | – | – | – | – | – | 0 | 0 | 0 |
| Bud Site | – | – | – | – | – | – | – | – | – | – | – | – | 0 | 0 | 0 |
| Cell Periphery | – | – | – | – | – | – | – | – | – | – | – | – | 0 | 0 | 0 |
| Cyto | – | – | – | – | – | – | – | – | – | – | – | – | – | – | – |
| Endoplasmic Reticulum | – | – | – | – | – | – | – | – | – | – | – | – | 0 | 0 | 0 |
| Endosome | – | – | – | – | – | – | – | – | – | – | – | – | 0 | 0 | 0 |
| Golgi | – | – | – | – | – | – | – | – | – | – | – | – | 0 | 0 | 0 |
| Mitochondria | – | – | – | – | – | – | – | – | – | – | – | – | 0 | 0 | 0 |
| Nuclear Periphery | – | – | – | – | – | – | – | – | – | – | – | – | 0 | 0 | 0 |
| Nuc | – | – | – | – | – | – | – | – | – | – | – | – | – | – | – |
| Nucleolus | – | – | – | – | – | – | – | – | – | – | – | – | 0 | 0 | 0 |
| Peroxisomes | – | – | – | – | – | – | – | – | – | – | – | – | 0 | 0 | 0 |
| SpindlePole | – | – | – | – | – | – | – | – | – | – | – | – | 0 | 0 | 0 |
| Vac | – | – | – | – | – | – | – | – | – | – | – | – | – | – | – |
| Cortical Patches | – | – | – | – | – | – | – | – | – | – | – | – | 0 | 0 | 0 |
| Cytoplasm | – | – | – | – | – | – | – | – | – | – | – | – | 0 | 0 | 0 |
| Nucleus | – | – | – | – | – | – | – | – | – | – | – | – | 0 | 0 | 0 |
| Vacuole | – | – | – | – | – | – | – | – | – | – | – | – | 6.8 | 7.8 | 8.0 |
External localization resources
Images






























Protein Concentration and Protein Localization Data
| R1 | R2 | R3 | ||||||||||||||||
|---|---|---|---|---|---|---|---|---|---|---|---|---|---|---|---|---|---|---|
| G1 Pre-START | G1 Post-START | S/G2 | Metaphase | Anaphase | Telophase | G1 Pre-START | G1 Post-START | S/G2 | Metaphase | Anaphase | Telophase | G1 Pre-START | G1 Post-START | S/G2 | Metaphase | Anaphase | Telophase | |
| Concentration | 1.1048 | -0.8347 | -1.0143 | -0.5707 | -0.8904 | -0.6386 | -0.1709 | -0.4429 | -0.6081 | -0.5591 | -1.0211 | -0.6589 | -1.0285 | -0.7196 | -1.1832 | -0.9538 | -1.3975 | -0.9538 |
| Actin | 0.1354 | 0.0023 | 0.0184 | 0.0056 | 0.0018 | 0.0006 | 0.0342 | 0.0002 | 0.0029 | 0.0051 | 0.0017 | 0.001 | 0.0181 | 0.0002 | 0.0109 | 0.0003 | 0.0754 | 0.0009 |
| Bud | 0.0024 | 0.0026 | 0.0003 | 0.0002 | 0.0002 | 0.0002 | 0.0012 | 0.002 | 0.0012 | 0.0002 | 0.0097 | 0.0002 | 0.0004 | 0.0078 | 0.0012 | 0.0001 | 0.0011 | 0.0001 |
| Bud Neck | 0.002 | 0.0002 | 0.0008 | 0.0003 | 0.0011 | 0.0014 | 0.0054 | 0.0003 | 0.0008 | 0.0004 | 0.0013 | 0.0028 | 0.0003 | 0.0002 | 0.0004 | 0.0003 | 0.0024 | 0.0015 |
| Bud Periphery | 0.0026 | 0.0044 | 0.0002 | 0.0002 | 0.0001 | 0.0004 | 0.0025 | 0.0013 | 0.0029 | 0.0004 | 0.0112 | 0.0003 | 0.0007 | 0.0005 | 0.0003 | 0 | 0.0032 | 0.0001 |
| Bud Site | 0.0094 | 0.0031 | 0.0014 | 0.0004 | 0.0062 | 0.0002 | 0.0109 | 0.0048 | 0.0118 | 0.0003 | 0.0054 | 0.0002 | 0.0009 | 0.0058 | 0.0027 | 0.0001 | 0.001 | 0.0001 |
| Cell Periphery | 0.0004 | 0.0002 | 0.0001 | 0.0001 | 0.0001 | 0.0004 | 0.0007 | 0.0001 | 0.0002 | 0.0001 | 0.0001 | 0 | 0.0001 | 0.0001 | 0.0001 | 0 | 0.0002 | 0 |
| Cytoplasm | 0.0869 | 0.1374 | 0.2955 | 0.0713 | 0.0867 | 0.2512 | 0.2189 | 0.2925 | 0.2022 | 0.1225 | 0.2704 | 0.3081 | 0.3363 | 0.3577 | 0.2808 | 0.2051 | 0.2881 | 0.3679 |
| Cytoplasmic Foci | 0.0795 | 0.0071 | 0.012 | 0.0139 | 0.1504 | 0.0048 | 0.0375 | 0.0119 | 0.0179 | 0.0052 | 0.0321 | 0.0143 | 0.0231 | 0.0054 | 0.0147 | 0.0206 | 0.0189 | 0.0243 |
| Eisosomes | 0.0009 | 0.0004 | 0.0002 | 0.0001 | 0.0001 | 0.0002 | 0.0005 | 0 | 0.0001 | 0.0002 | 0 | 0 | 0.0001 | 0.0001 | 0.0002 | 0 | 0.0002 | 0 |
| Endoplasmic Reticulum | 0.0194 | 0.0049 | 0.0048 | 0.0024 | 0.0013 | 0.0133 | 0.0073 | 0.0054 | 0.0039 | 0.0014 | 0.008 | 0.003 | 0.0035 | 0.0041 | 0.004 | 0.0015 | 0.0032 | 0.0031 |
| Endosome | 0.0632 | 0.0016 | 0.0023 | 0.0386 | 0.0144 | 0.0555 | 0.0386 | 0.0053 | 0.0127 | 0.0132 | 0.0162 | 0.0137 | 0.0138 | 0.009 | 0.006 | 0.0296 | 0.0075 | 0.007 |
| Golgi | 0.0404 | 0.0002 | 0.0009 | 0.0442 | 0.0054 | 0.0038 | 0.0145 | 0.0003 | 0.0064 | 0.0209 | 0.0095 | 0.0052 | 0.0133 | 0.0012 | 0.0066 | 0.0398 | 0.0054 | 0.0086 |
| Lipid Particles | 0.0312 | 0.0014 | 0.0034 | 0.0268 | 0.0207 | 0.0053 | 0.0311 | 0.0008 | 0.0069 | 0.0058 | 0.0366 | 0.0024 | 0.025 | 0.0004 | 0.0046 | 0.0019 | 0.0019 | 0.0036 |
| Mitochondria | 0.0468 | 0.0014 | 0.0019 | 0.008 | 0.0004 | 0.003 | 0.0142 | 0.0005 | 0.0094 | 0.0459 | 0.0098 | 0.0103 | 0.0124 | 0.0005 | 0.0038 | 0.0065 | 0.0046 | 0.004 |
| None | 0.371 | 0.7544 | 0.539 | 0.702 | 0.545 | 0.5437 | 0.3661 | 0.4977 | 0.4594 | 0.5527 | 0.2931 | 0.3119 | 0.3899 | 0.474 | 0.4783 | 0.4553 | 0.2668 | 0.3941 |
| Nuclear Periphery | 0.0198 | 0.005 | 0.0096 | 0.0037 | 0.0035 | 0.0239 | 0.0307 | 0.0087 | 0.0106 | 0.0067 | 0.013 | 0.0105 | 0.007 | 0.008 | 0.0081 | 0.0042 | 0.0159 | 0.006 |
| Nucleolus | 0.0011 | 0.0011 | 0.0021 | 0.0006 | 0.0018 | 0.0046 | 0.0058 | 0.0013 | 0.0026 | 0.0005 | 0.0046 | 0.0022 | 0.0005 | 0.0007 | 0.0026 | 0.0005 | 0.0061 | 0.0008 |
| Nucleus | 0.0352 | 0.0599 | 0.0889 | 0.0714 | 0.0101 | 0.0564 | 0.1267 | 0.1503 | 0.2154 | 0.2075 | 0.193 | 0.2742 | 0.1213 | 0.1165 | 0.1554 | 0.2172 | 0.2717 | 0.1542 |
| Peroxisomes | 0.0319 | 0.0006 | 0.0018 | 0.0035 | 0.0068 | 0.0002 | 0.0296 | 0.0054 | 0.0163 | 0.0018 | 0.0226 | 0.0076 | 0.0267 | 0.0002 | 0.0053 | 0.0007 | 0.0024 | 0.0022 |
| Punctate Nuclear | 0.0135 | 0.0097 | 0.0148 | 0.0044 | 0.1433 | 0.0107 | 0.0106 | 0.0083 | 0.0129 | 0.0077 | 0.0579 | 0.0286 | 0.0045 | 0.0057 | 0.0121 | 0.0144 | 0.0173 | 0.0199 |
| Vacuole | 0.0043 | 0.0016 | 0.0011 | 0.0014 | 0.0006 | 0.0126 | 0.0078 | 0.0025 | 0.0028 | 0.0008 | 0.0028 | 0.0023 | 0.0018 | 0.0017 | 0.0017 | 0.0011 | 0.005 | 0.0012 |
| Vacuole Periphery | 0.0026 | 0.0004 | 0.0003 | 0.0008 | 0.0001 | 0.0078 | 0.0053 | 0.0003 | 0.0006 | 0.0006 | 0.0009 | 0.0011 | 0.0005 | 0.0002 | 0.0003 | 0.0006 | 0.0021 | 0.0003 |
Sequencing Data
| R1 | R2 | |||||||||
|---|---|---|---|---|---|---|---|---|---|---|
| G1 Post-START | S/G2 | Metaphase | Anaphase | Telophase | G1 Post-START | S/G2 | Metaphase | Anaphase | Telophase | |
| Gene Expression | 15.1822 | 12.2586 | 7.7969 | 11.2639 | 10.4772 | 13.2159 | 14.9399 | 12.5483 | 10.215 | 16.8983 |
| Translational Efficiency | 0.2896 | 0.3888 | 0.3667 | 0.2614 | 0.2445 | 0.4194 | 0.362 | 0.3478 | 0.3962 | 0.2848 |
Hit Data
| Dataset | Hit |
|---|---|
| Protein Concentration | ✘ |
| Protein Localization | ✘ |
| Gene Expression | ✔ |
| Translational Efficiency | ✘ |
Endocytosis
| Temp | Actin Patch (Sac6-tdTomato) | Cortical Patch (Sla1-GFP) | Late Endosome (Snf7-GFP) | Vacuole (Vph1-GFP) |
|---|---|---|---|---|
| 37℃ | ||||
| RT |
Cell Cycle Omics
CYCLoPs (Ptp2-GFP)
| Gene / Allele | Actin Patch (Sac6-tdTomato) | Cortical Patch (Sla1-GFP) | Late Endosome (Snf7-GFP) | Vacuole (Sac6-tdTomato) |
|---|
| Gene | Images |
|---|
| Gene | Images |
|---|
Images are not yet available
Images are not yet available